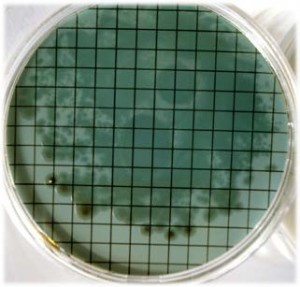
Pseudomonas aeruginosa en 48h

CETRIMIDE-NALIDIXIC PSEUDOMONAS CN AGAR (BASE) Aislamiento selectivo para Pseudomonas aeruginosa (UNE-EN 12780, ISO 16266) en aguas envasadas
Aislamiento selectivo para Pseudomonas aeruginosa (pr EN 12780:1999, UNE-EN 12780:2003, BOE 259 de 29/X/2002, ISO 16266:2006) en aguas envasadas
COMPOSICIÓN
Peptona pancreática gelatina 16,0 g Hidrolizado de caseína 10,0 g Cetrimida 0,2 g Cloruro magnésico 1,4 g Sulfato potásico 10,0 g Agar-agar 15,0 g (Fórmula por litro)
pH final: 7,1 ± 0,2
PARA USO EXCLUSIVO EN LABORATORIO MANTENGA EL BOTE BIEN CERRADO EN LUGAR SECO, FRESCO Y OSCURO. AGITE EL BOTE ANTES DE USAR.
PREPARACIÓN
Disolver 52,6 g de medio en 1 litro de agua destilada. Añadir 10 ml de glicerol. Calentar hasta ebullición, agitando para su disolución. Autoclavar a 121 ºC durante 15 minutos. Dejar enfriar el medio a 45-50 ºC y, si se desea seguir la Norma prEN 12780:1997 y la ISO 16266 al pie de la letra, añadir 0’015 g/l de Ácido Nalidíxico (SMS034Z).
DESHIDRATADO CODIGO: DMT220
CONTROL DE CALIDAD DEL MEDIO
Realizado en nuestro laboratorio; es prudente repetirlo en su laboratorio siempre que varíen las condiciones (más de 3 meses sin usar, tras desinfectar laboratorio, tras conservar a alta Tª, cuando adquiere aspectos extraños aunque no haya llegado la fecha de caducidad teórica de la etiqueta,…)
DESHIDRATADO: Polvo grueso, Blanco PREPARADO: Estéril, Blanco CONTROL DE CRECIMIENTO CUANTITATIVO 48 h a 37°C aproximadamente, o bien a temperatura ambiente (aprox.21-28°C):
- Staphylococcus aureus MKTA 6538P, Inhibido.
- E.coli MKTA 25922, Inhibido.
- Pseudomonas aeruginosa MKTA 27853, Bueno, Pigmenta, Colonias verde-amarillentas, fluorescentes. Con respecto a TSA estandarizado*, recuento 65-99%, pero selectivo.
- Burkholderia cepacia MKTA 25416, Correcto, colonias blancas-crema. Con respecto a TSA estandarizado*, recuento 55%, pero selectivo.
* El que cumple con recuperación superior al 92-125% con respecto a cepas cuantitativas trazables a la cepa tipo.
PRESENTACIÓN: Medio deshidratado (BASE), TUBOS 20 ml, FRASCOS 100 ml, PLAQUITAS HERMÉTICAS MF, Viales 2 ml MF, viales pinchables 100 ml.
SIEMBRA E INTERPRETACIÓN
Fundir tubos y frascos y verter 20ml en cada placa de Petri estéril. Dejar enfriar. Sembrar en superficie. En el caso de las placas de contacto, tocar la superficie un instante, sin mover o introducirlas en un aparato para control del aire. Incubar a 35-37 ºC aproximadamente, durante 18-24 h y 40-48 horas. La incubación a 42 °C aprox. es más selectiva, pero se puede escapar alguna cepa de Ps.aeruginosa. Pseudomonas aeruginosa crece con colonias verde-amarillentas, confirmativas. Si no son de ese color pero sí son fluorescentes (sobre todo bajo luz de 366nm, linterna MICROKIT), confirmar con caldo Acetamida (DMT003). Si no son verdes ni fluorescentes, pero sí marrones, confirmar con tiras de citocromo-oxidasa KOT050 (no usar asa de nicrom, sino exclusivamente de Platino: VCS147), con caldo Acetamida (DMT003) y con fluorescencia en King B Agar (DMT182). También son muy útiles las galerías de identificación (MICROKIT KBH262).
El usuario es el único responsable de la eliminación de los microorganismos según la legislación medioambiental vigente. Autoclavar antes de desechar a la basura.
Si desea más información sobre nuestros MEDIO CETRIMIDE-NALIDIXIC PSEUDOMONAS CN AGAR rellene nuestro formulario de contacto http://www.medioscultivo.com/contacto . O si lo prefiere póngase en contacto con nosotros a través de nuestro correo electrónico microkit@microkit.es o por teléfono en el nº 91-897 46 16
https://www.microkit.es/fichas/CETRIMIDE-CN-AGAR.pdf
https://www.microkit.es/monograficos/13-Pseudomonas-aeruginosa-monograf–a.pdf